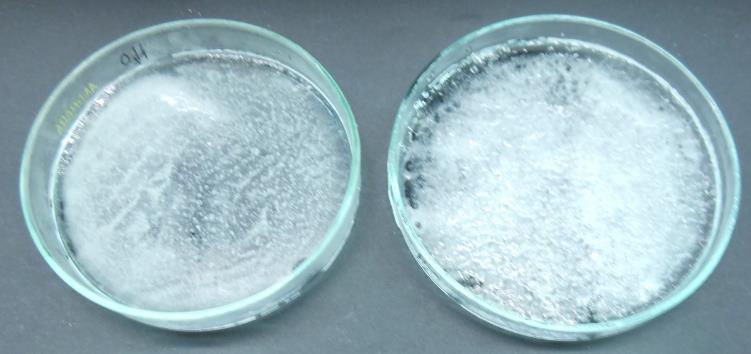

| Thema: Sonne, Wetter, Jahreszeiten | Tags: Eis, Wasser, Glätte, tauen | Klassenstufen: 5-6 | Versuchsart: SV |
Materialien
2 Petrischalen, Spatel
Chemikalien
Wasser, Kochsalz (NaCl)
Durchführung
Fülle die zwei Petrischalen mit Wasser und lass diese über Nacht im Tiefkühlfach gefrieren. Streu mithilfe eines Spatels gleichmäßig wenige Spitzen Kochsalz auf eine der beiden Petrischalen. Beobachte, welche Unterschiede sich zwischen beiden Schalen zeigen, wenn du sie bei Raumtemperatur stehen lässt.
Beobachtung
Das Salz lässt das Eis an der Oberfläche sofort schneller schmelzen, die Oberfläche der Eisschicht wird rau. Nach wenigen Minuten ist das gesamte Eis in der Petrischale geschmolzen, in der Vergleichsschale ohne Salz sind noch gefrorene Eisreste zu sehen.
Deutung
Auch bei Minusgraden ist immer etwas flüssiges Wasser auf der Eisschicht vorhanden. In diesem Wasserfilm lösen sich das Salz in kleinste Teilchen auf. Bei Anwesenheit von Salz kann das Wasser nicht wieder gefrieren. Das Streusalz verhindert also das erneute Gefrieren des Schmelzwassers. Aus dem schmelzenden Eis wird ständig ein neuer dünner Wasserfilm gebildet, in dem wiederum Salz aufgelöst wird. Dieser Prozess geht immer weiter, solange genügend Salz vorhanden ist. Dadurch löst sich das Eis langsam völlig.
Entsorgung
Die Lösungen können im Abfluss entsorgt werden.
Feedback
Haben Sie Anmerkungen, Feedback oder Kritik zu diesem Experiment? Kontaktieren Sie uns unter Bezugnahme auf diese Seite!
Copyright und Lizenzen: Alle Rechte an den Inhalten dieser eLearning-Materialien liegen beim Autor oder den jeweiligen Urheberrechtsinhabern. Sämtliche Bilder und Texte sind entweder vom Autor selbst fotografiert oder verfasst oder sind gemeinfrei, es sei denn, es ist eine andere Quelle angegeben. Die gesammelten/vollständigen Literaturverzeichnisse der einzelnen Versuche sind jeweils in den entsprechenden Gesamtprotokollen zu finden.
Haftungsausschluss: Die Benutzung der hier vorliegenden Informationen geschieht auf vollkommen eigene Verantwortung. Haftung für Schäden oder Verluste, die beim Umgang mit den hier beschriebenen Stoffen oder bei der Durchführung von chemischen Versuchen entstehen, ist ausgeschlossen; ebenso wie Schadensersatzforderungen oder Gewährleistungsansprüche aufgrund falscher oder fehlender Angaben. Die Angaben zu den Stoffen und die Experimentieranleitungen wurden jedoch sorgfältig und nach bestem Gewissen erstellt und sind in jedem Falle zu beachten.